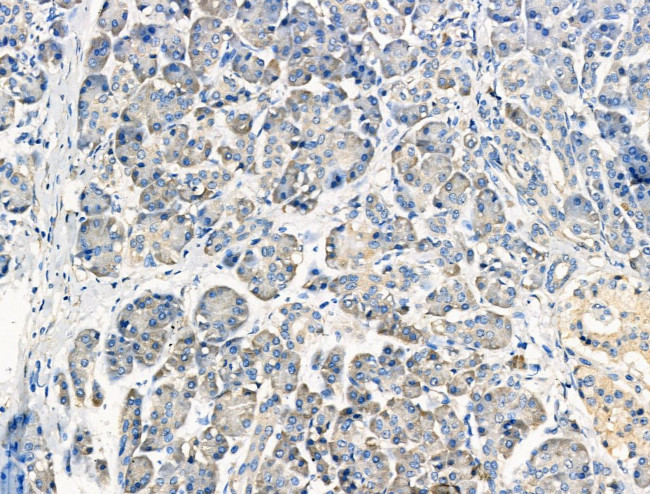
PPY Antibody in Immunohistochemistry (Paraffin) (IHC (P))

Search
Invitrogen
PPY Polyclonal Antibody
{{$productOrderCtrl.translations['antibody.pdp.commerceCard.promotion.promotions']}}
{{$productOrderCtrl.translations['antibody.pdp.commerceCard.promotion.viewpromo']}}
{{$productOrderCtrl.translations['antibody.pdp.commerceCard.promotion.promocode']}}: {{promo.promoCode}} {{promo.promoTitle}} {{promo.promoDescription}}. {{$productOrderCtrl.translations['antibody.pdp.commerceCard.promotion.learnmore']}}
图: 1 / 3
PPY Antibody (PA5-115719) in IHC (P)



Please note: We are reviewing Western blot images included in the antibody testing data in our catalog, including those provided by third parties. Unless expressly labeled or annotated as “raw-unedited”, Western blot images included in the antibody testing data in our catalog may have been edited, optimized or otherwise adjusted for presentation.
产品信息
PA5-115719
种属反应
宿主/亚型
分类
类型
抗原
偶联物
形式
浓度
规格
纯化类型
保存液
内含物
保存条件
运输条件
RRID
产品详细信息
Antibody detects endogenous levels of total Pancreatic Polypeptide.
靶标信息
The PPY gene encodes pancreatic polypeptide, a peptide hormone involved in the regulation of appetite and energy balance. The origin of the PPY gene is linked to a tandem duplication of the PYY gene, occurring concomitantly with the emergence of tetrapods, leading to the distinct PPY function within the neuropeptide Y family. In primates and ungulates, a gene duplication event resulted in the formation of a PYY2-PPY2 gene cluster, highlighting the evolutionary complexity of these genes. The PPY gene product is secreted by gamma-cells in the pancreas, localized primarily in the islet periphery, and plays a crucial role in metabolic homeostasis by interacting with receptors in the central nervous system to modulate satiety signals postprandially. PPY's function is linked to its inhibition of AGRP/NPY neurons which decreases their suppressive effect on POMC neurons, enhancing POMC activity and contributing to appetite suppression. This intricate regulation underscores the importance of PPY in dietary intake and metabolic disorders, with ongoing research exploring its potential therapeutic applications.
仅用于科研。不用于诊断过程。未经明确授权不得转售。
篇参考文献 (0)
生物信息学
蛋白别名: HGNC:9327; IOPPP; Pancreatic polypeptide prohormone; Pancreatic polypeptide Y; pancreatic prohormone; PH; PP; PP1; PPA1; PPase; SID6-8061
基因别名: AV061413; IGSPP; PNP; PP; PPY
UniProt ID: (Rat) P06303, (Mouse) P10601
Entrez Gene ID: (Rat) 24677, (Mouse) 19064